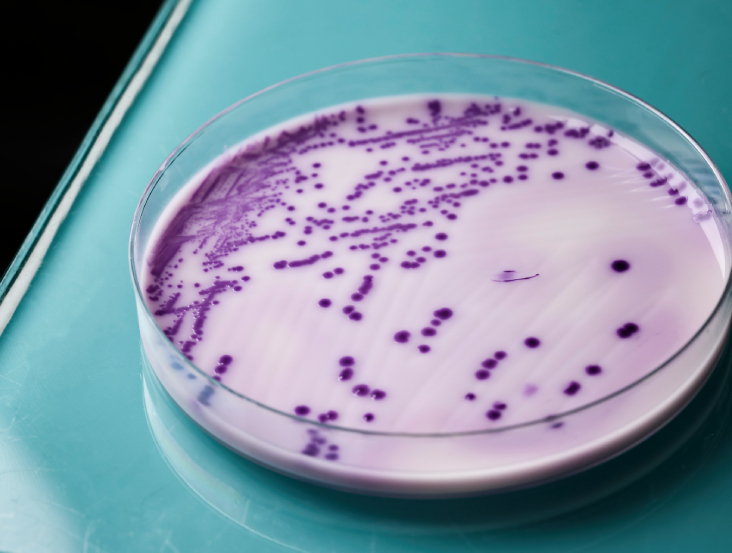

Votre panier est actuellement vide !
Les analyses adaptées à vos besoins
Fiabilité, expertise, réactivité. Depuis plus d’un siècle, nous accompagnons les professionnels avec des analyses précises et certifiées, garantissant la sécurité et la conformité de leurs produits et environnements.
40
+
collaborateurs
95
%
satisfaction clients
860
+
clients

Transmettre,
accompagner, améliorer
Parce que la maîtrise des risques passe aussi par la connaissance et l’évaluation, le LABCO propose des formations professionnelles sur-mesure et des accompagnements personnalisés dans les domaines de l’hygiène, de la sécurité sanitaire et de la conformité réglementaire (certification Qualiopi).
Nous intervenons directement au sein de votre structure, partout en France, avec une approche pédagogique rigoureuse et des recommandations concrètes.
Faites de vos obligations un levier de performance.
Comment ça marche ?
Un processus simple, rapide et fiable pour garantir la sécurité de vos produits.
Nos équipes se déplacent afin de réaliser les prélèvements directement sur le terrain selon des protocoles rigoureux et adaptés à votre activité.
Au LABCO, nous accompagnons également nos clients à réaliser eux-mêmes leurs prélèvements dans des conditions sécurisées.
Une fois les échantillons dans notre laboratoire, ils sont analysés selon les normes en vigueur, des méthodes validées et des normes techniques reconnues.
Nos équipements performants permettent d’analyser les paramètres microbiologiques et physico-chimiques essentiels à la maîtrise de la qualité et de la sécurité.
Une fois les analyses réalisées, l’interprétation des résultats constitue une étape clé pour transformer les données brutes en informations utiles et exploitables.
Parce que chaque situation est unique, nos responsables techniques restent disponibles pour échanger avec vous, répondre à vos questions et vous accompagner dans la compréhension des résultats.
Nos derniers articles
Découvrez nos dernières avancées et projets marquants.
Cette rubrique vous tient informé(e) de la vie du laboratoire et de notre engagement quotidien pour la qualité et l’innovation.
Réduction des temps d’incubation listeria

Adultération des laits, détection de laits d’especes differentes

Réduction des temps des cycles PCR pathogene

Avez-vous des questions ?
Lorem ipsum dolor sit amet consectetur odio vel nunc platea orci quis dolor ac aliquet in sit viverra et neque sit sit enim ornare
Nous réalisons des analyses microbiologiques, physico-chimiques et environnementales sur les produits alimentaires, les eaux, les surfaces, et les milieux de production.
Oui. Le LABCO est accrédité par le COFRAC (Comité Français d’Accréditation) pour ses analyses en microbiologie et chimie alimentaire, conformément à la norme ISO 17025. Cette accréditation garantit la compétence technique du laboratoire, la fiabilité des résultats et le respect des exigences réglementaires.
Nos méthodes sont validées et vérifiées selon des protocoles stricts, incluant des essais inter-laboratoires (EIL), des contrôles internes de qualité (CIQ) et des essais externes (EEQ). Chaque méthode fait l’objet d’une décision d’aptitude formalisée par notre Direction Technique ou notre Responsable Qualité.
Nous sommes également certifiés QUALIOPI pour nos prestations de formation, ce qui atteste de la qualité de nos actions pédagogiques.
Nous analysons toutes les matrices : produits laitiers, viandes, poissons, plats cuisinés, pâtisseries, végétaux, etc.
Nos garanties
Au LABCO, la rigueur scientifique et la conformité réglementaire ne sont pas des options, mais des engagements.
Nos accréditations et certifications sont le reflet de notre exigence quotidienne en matière de qualité, de fiabilité et de traçabilité.
Un engagement fort en formation

LABCO est certifié Qualiopi pour son activité de formation. Cette certification nationale garantit la qualité des processus pédagogiques que nous proposons à nos clients et partenaires.
Elle atteste de notre capacité à concevoir et animer des formations professionnelles structurées, claires, et alignées avec les besoins du secteur.
Gage d’exigence technique

N° 1-6933
Portée
disponible sur
www.cofrac.fr
Cette accréditation atteste que nos méthodes d’analyses sont réalisées selon des protocoles stricts et validés, en conformité avec les normes en vigueur. Elle garantit à nos clients des résultats fiables, traçables et reconnus par les autorités sanitaires.